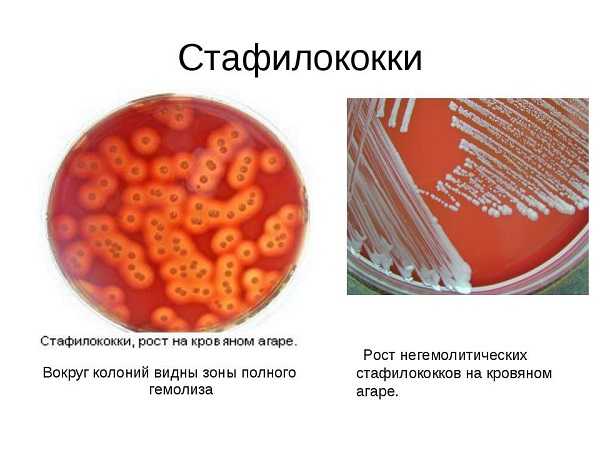

Золотистый стафилококк в носу у ребенка: признаки и лечение инфекции
Стафилококки относятся к условно-патогенной микрофлоре. Они постоянно присутствуют на слизистых оболочках и кожных покровах. При снижении защитных функций организма приобретают патогенную форму и вызывают развитие многих заболеваний. Золотистый стафилококк из всех видов стафилококков считается самым опасным особенно для детей.
Золотистый стафилококк: что это и чем опасен?

Золотистый стафилококк – опасная бактерия
Золотистый стафилококк относится к самым опасным бактериям, который способен вызвать различные серьезные заболевания. Данный вид стафилококка имеет несколько штаммов, которые отличаются друг от друга набором производимых токсинов.
Под микроскопом бактерия выглядит в виде округлых скоплений желтого цвета. Стафилококк характеризуется высокой жизнеспособностью, и может сохраняться около 6 месяцев в высушенном состоянии. Бактерии не погибают под воздействием прямых солнечных лучей, при замораживании.
Если не уничтожить инфекцию, то она будет активно размножаться и поражать другие органы.
Несвоевременное лечение стафилококковой инфекции может стать причиной серьезных осложнений:
- Хронического гайморита
- Пневмонии
- Менингита
- Флегмоны
- Сепсиса
При выявлении большого количества штаммов болезнетворной бактерии следует своевременно начать лечение, чтобы не допустить развитие серьезных заболеваний.
Причины и симптомы

Бакпосев из носа – эффективная диагностика стафилококковой инфекции
Золотистый стафилококк относится к самым опасным бактериям, так как способствует развитию серьезных заболеваний. Такое название он получил по своему цвету. Чаще всего он локализуется в носовой полости, а в дальнейшем проникает в кровоток и распространяется по всему телу.
Заражение может происходить воздушно-капельным, контактно-бытовым и оральным путями. Попасть инфекция к ребенку может во время поцелуя, чихания, при кормлении грудью, через родовые пути, с продуктами питания. В медучреждениях при нарушении стерильности во время процедур также велика вероятность попадания золотистого стафилококка внутрь.
Стафилококки относятся к условно-патогенным микроорганизмам и присутствуют на слизистых оболочках. При сопутствующих факторах их количество превышает норму, что и приводит к воспалительному процессу.
Основные факторы, способствующие проникновению стафилококковой инфекции в организм:
- Ослабление иммунитета.
- Неправильное питание.
- Кариес.
- Длительное использование сосудосуживающих средств.
При диагностике золотистого стафилококка у детей необходимо пройти обследование другим членам семьи. И лечение должны пройти все члены, так как будет риск повторного заражения.
Больше информации о золотистом стафилококке можно узнать из видео:
Золотистый стафилококк очень коварная инфекция и его очень легко спутать с простудой или респираторными заболеваниями. Симптоматика зависит от количества размножений болезнетворных бактерий. К основным признакам золотистого стафилококка в носу относят:
- Слизистые выделения из носа.
- Зуд и покраснение слизистой.
- Повышение температуры.
- Затруднение дыхания.
- Ощущение заложенности носа.
- Увеличение миндалин и аденоидов.
- Образование корочек в носовых проходах.
- Интоксикация.
- Продолжительный насморк.
Симптоматика взрослых и детей отличается. Характерным признаком стафилококковой инфекции будет сыпь на коже. Обнаружить золотистый стафилококк можно только путем лабораторных исследований – бакпосева слизи из носовой полости.
Медикаментозное лечение и антибиотики
Правильно и эффективное лечение может назначить только врач!
Если в результате посева мазка из носа был обнаружен золотистый стафилококк, то проводится оценка чувствительности микроорганизма к антибиотикам. Это важный этап при назначении антибактериальной терапии, так как различные возбудители обладают резистентностью к определенным препаратам.
Лечение золотистого стафилококка в носу направлено на устранение причины его появления и признаков воспалительного процесса. Для каждого ребенка лечение назначается индивидуально. Обычно медикаментозное лечение проводится в домашних условиях, но в более тяжелых случаях потребуется госпитализация.
Особенности лечения:
- Для лечения используются антибактериальные препараты широкого спектра действия: Амоксиклав, Оксациллин, Цефтриаксон, Нофлоксацин и др. Лечение антибиотиками составляет 2-3 недели. При улучшении самочувствия прекращать использование препарата запрещается, так как в противном случае разовьется устойчивость к антибиотику и лечение затянется.
- Из антибиотиков местного действия применяют Мупироцин или Биопарокс. Этими препаратами смазывают носовую полость 2-3 раза в день в течение недели.
- Во избежание аллергической реакции на антибиотики принимают антигистаминные препараты. Они уменьшают количество выделений и зуд. Чтобы ранки и язвочки быстрее зажили, их следует обрабатывать «зеленкой».
- Кроме того, ЛОР может назначить закапывание в нос Хлорофиллипта, промывание солевым раствором.
- Весь период лечения рекомендуется употреблять иммуномодуляторы и мультивитамины. После курса лечения необходимо сдать повторный мазок на золотистый стафилококк, чтобы удостовериться, что инфекции в организме больше нет.
Лечение стафилококковой инфекции в носу должно проводиться комплексно с соблюдением всех рекомендаций врача.
Народные методы лечения
Лечим стафилококковую инфекцию отваром из липы
К нетрадиционным методам лечения золотистого стафилококка у детей следует подходить с осторожностью и выбирать их в качестве основного лечения запрещается. Народные методы являются вспомогательным средством медикаментозной терапии.
Следует помнить, что золотистый стафилококк не погибает под воздействием спирта, перекиси водорода. Поэтому использовать эти средства для обработки ранок и язвочек нет смысла. Лучшее средство, которое боится стафилококк, — «зеленка».
Популярные народные средства при лечении золотистого стафилококка:
- Отвар эхинацеи и корня лопуха. Растения измельчить и залить 2 столовые ложки сырья 800 мл горячей воды. Далее прокипятить в течение 20 минут и остудить. Принимать внутрь 3 раза в сутки.
- Чесночный компресс. Зубчики чеснока измельчить, залить теплой кипяченой водой и оставить на 1,5-2 часа. Далее смочить хлопчатобумажную ткань и приложить на воспаленные участки носа. Процедуру повторять каждый день около 2 недель.
- Отвар липового цвета. В термос всыпать 2 столовые ложки сырья и залить стакан кипятка. По истечении 3 часов процедить и использовать для промывания носовой полости.
- Промывание эфирным маслом эвкалипта. Взять 5 г соли и 2 капли масла и растворить в 1/4 литра кипяченой воды. Промывать необходимо сразу после приготовления раствора.
- Прополис. 20 г прополиса растворить в 1/2 стакана воды и поставить на водяную баню на 2 часа. Ребенку давать по 1 столовой ложке перед приемом пищи.
Категорически запрещается ставить согревающие компрессы на переносицу, область лба. В период всего лечения следует употреблять больше жидкости. Для укрепления иммунитета и полезно давать ребенку липовый, малиновый чай, отвар шиповника, ромашки, листьев смородины.
Профилактика
Профилактические меры против золотистого стафилококка направлены на предупреждение попадания инфекции в организм.
Основные рекомендации, как избежать заражения стафилококковой инфекцией:
- Часто проветривать помещение и делать влажную уборку.
- Всегда мыть руки перед едой.
- Детские игрушки и посуду нужно держать в чистоте.
- Укреплять иммунную систему.
- Избегать переохлаждения организма.
- Принимать иммуностимулирующие препараты в период вирусных инфекций.
- Продукты, которые не подвергаются нагреву, необходимо обрабатывать в мыльной воде. Это существенно снизит риск попадания стафилококка в организм через продукты питания.
Важным методом профилактики является укрепление иммунной системы. Следует приучать детей с малого возраста к здоровому образу жизни. Необходимо каждый день делать зарядку, правильно питаться, совершать пешие прогулки, соблюдать правила личной гигиены.
Полезно делать закаливания, влажные обтирания и в летний период купаться в водоеме.
Необходимо соблюдать вышеперечисленные рекомендации и тогда можно предотвратить развитие многих заболеваний, в том числе попадание в организм болезнетворных бактерий, таких как золотистый стафилококк.
Заметили ошибку? Выделите ее и нажмите Ctrl+Enter, чтобы сообщить нам.
Поделись с друзьями! Будьте здоровы!
tvojlor.com
Золотистый стафилококк в носу: как лечить ребёнка, профилактика
Стафилококки – это бактерии, которые обитают повсюду. Они имеют высокую устойчивость к экстремальным условиям среды: засухе, заморозкам и отсутствию кислорода. Золотистый стафилококк живёт в окружающей природе, квартирах, офисах и на нашей коже. Из всех разновидностей стафилококка золотистый (ауреус) является одним из самых опасных, особенно для ребёнка. Что же представляет собой золотистый стафилококк?
Человек и стафилококк
Организм ребёнка, как и любой человеческий организм, взаимодействует с окружающим миром на различных уровнях, в том числе и на микробиологическом. Наш иммунитет является защитным барьером при взаимодействии с бактериями различных видов. Постоянно подвергаясь микробиологическим «атакам», иммунитет с одними угрозами успешно борется, а с некоторыми справиться не может.
Микробы делятся на патогенные и условно-патогенные. Патогенные бактерии могут вызвать инфекционные заболевания, а условно-патогенные станут причиной болезни только при совокупности определённых факторов.
Создать полностью стерильную среду для повседневной жизни человека невозможно. Он находится в постоянном взаимодействии с огромным количеством патогенных и условно-патогенных бактерий. Одной из самых распространённых среди них является золотистый стафилококк. Иммунитет человека индивидуален, на его уровень влияют гены, образ жизни и общее здоровье организма. Золотистый стафилококк постоянно или периодически обитает в носу человека примерно у 80% людей. И всего лишь у 20% иммунитет такой силы, что препятствует обосноваться на слизистой оболочке носа.
Заразиться стафилококком легко
Заразен ли золотистый стафилококк в носу? На самом деле, восемь из десяти человек являются носителями этой инфекции в неактивной форме, оставшиеся два имеют резистентность (сопротивляемость) к ней. Стафилококки попадают в наш организм различными способами.
Наиболее распространённые из них:
- при дыхании вместе с частицами пыли;
- при взаимодействии с другими людьми, так как бактерии находятся у нас на коже;
- при употреблении плохо термически обработанной пищи (при кипячении стафилококк погибает).
Следовательно, «подхватить» стафилококк достаточно легко. Сильно переживать из-за этого не нужно, так как избежать этого невозможно. Условно-патогенный вид бактерии делает её неопасной для носа человека.
Но интересен другой вопрос: по какой причине золотистый стафилококк, который постоянно или периодически находится в носу, переходит в патогенную стадию с развитием полного инфекционного процесса? Причина заключается в имунноугнетённом состоянии, которое возникает при вирусной инфекции.
Механизм инфицирования
Все вирусы имеют свои особенности, даже те, что в обиходе называют простудой. Одна из них заключается в том, что вирусы могут подавлять иммунитет, блокируя вырабатываемый им интерферон. Делается это вирусом для получения возможности беспрепятственного проникновения в здоровые клетки организма и запуска в них процесса саморепликации (самовоспроизведения).
Золотистый стафилококк пользуется угнетённым иммунитетом и проникает глубоко в слизистую оболочку, далее по системе дыхательных путей он может добраться до среднего уха человека. Получается, что вирусная инфекция и есть тот катализатор, который влечёт за собой переход стафилококка из условно-патогенной фазы в патогенную, вызывающую в носу инфекцию золотистого стафилококка.
Причиной появления инфекции золотистого стафилококка являются следующие вирусы:
- Любые респираторные вирусы.
- Вирус герпеса (являющийся самым иммунноугнетающим).
- Вирус иммунодефицита.
Норма и главные симптомы
Норма содержания золотистого стафилококка в носу как у ребёнка, так и у взрослого равна от 10^2 до 10^3 степени КОЕ/мл. Говоря о норме, нужно понимать, что его наличие в любом количестве не должно вызывать беспокойства. Если нет симптомов острого респираторного инфекционного процесса, то не имеет значения, какое количество этих бактерий находится в носу.
Обратите внимание! Основной признак активной деятельности в носу золотистого стафилококка – это гнойное воспаление.
Переходя в патогенное состояние, стафилококк вызывает такие симптомы, как:
- Повышение температуры до 39° и более.
- Насморк.
- Заложенность носовых пазух.
- Выделения из носа гноя и слизи.
- Гнойные скопления в придаточных пазухах.
- Болезненные ощущения в области гайморовых и лобных пазух.
- Головная боль.
- Общая интоксикация.
Часто инфекция распространяется дальше на слизистую оболочку глотки и евстахиеву трубу, попадая прямиком в полость среднего уха. При этом, соответственно, локализуется и гнойный процесс. В том случае если человек имеет хронический гайморит, золотистый стафилококк вызывает обострение заболевания.
Диагностика
Инфекция золотистого стафилококка по своим диагностическим показаниям имеет сходство с другими бактериальными инфекциями, вызываемыми пневмококками, стрептококками, гемофильной палочкой. Идеальные условия для точного выявления разновидности возбудителя – взятие анализа гнойного посева из носа. Его результаты будут известны через несколько дней.
В этом и заключается проблема, так как инфекционный процесс не стоит на месте. И если не бороться с инфекцией, то она с течением времени переходит на ближайшие органы и ткани человека. Именно из-за этого чаще всего такие анализы не делаются, а назначается стандартное в этом случае противобактериальное лечение.
В большинстве случаев инфекция золотистого стафилококка после возникновения не ограничивается лишь носовой полостью, а проникает во все дыхательные пути, также может попасть и в желудочно-кишечный тракт. Она распространяется по всем органам через кровь, то есть заболевание приобретает генерализованный фактор.
Обратите внимание! Для того, чтобы распознать и выявить инфекционный процесс, необходимо провести полное медицинское обследование и опрос заразившегося, с назначением всего комплекса анализов.
Лечение золотистого стафилококка в носу: виды препаратов
Важно! Нужно осознавать, что лечится не сам золотистый стафилококк, а только патогенный стафилококк, который проявляется гнойными воспалениями и высокой температурой.
Для лечения стафилококка как у взрослого, так и у ребёнка, используются следующие виды препаратов:
- Антибиотики.
- Антигистамины.
- Иммуностимуляторы.
Антибиотики – это традиционные препараты, используемые при бактериальных инфекциях. Прежде всего применяют синтетический пенициллин, содержащий клавуланат.
Антигистаминные препараты – это лекарства, блокирующие рецепторы гистамина в человеческом организме.
Это приводит к уменьшению гистаминных эффектов, например, спазмов.
Какие именно препараты применяются
Указанные выше виды содержат такие препараты, как:
- Амоксиклав.
- Панклав.
- Флемоклав.
Стафилококки могут быть устойчивы к антибиотикам некоторых видов. Если в течение двух дней после начала приёма антибиотиков состояние больного не улучшается, необходимо заменить препарат на более эффективный — это антибиотики из цефалоспориновой и макролидовой групп.
Медикаменты, стимулирующие иммунную систему при стрептококковой инфекции в носу:
- Стрептококковый бактериофаг.
- ИРС-19.
- Витаминные комплексы.
При несильном угнетении иммунитета назначают более сложные схемы иммуностимуляторов, в том числе:
- Антистафилококковый иммуноглобулин.
- Антигистамины.
- Иммуностимуляторные пептиды.
- Синтетические иммуномодуляторы.
Препараты местного применения
Большую роль при лечении стафилококка играют процедуры местного применения, производимые в данной последовательности:
- Сосудосуживающие капли.
- Промывание носовых каналов солёной водой.
- Промывание носовых каналов хлоргексидином.
- Закапывание раствором хлорофиллипта.
Хлоргексидин – является противомикробным антисептическим средством с действием широкого диапазона.
Хлорофиллипт – это препарат, в основе которого содержится экстракт эвкалиптовых листьев, активно влияющих на стрептококки. Закапывают от двух до пяти капель в каждый носовой канал, три раза в день, в течение одной недели.
Если в носовых пазухах присутствуют гнойные воспаления, то целесообразно применение антибактериальной мази. Используется 2% мазь
Лечение народными средствами
Использование средств народной медицины для лечения золотистого стафилококка возможно только с целью иммуностимуляции. Если не применять антибиотики, любимые народные лекарства будут бесполезны.
К иммуностимулирующим растениям относят:
- Элеутерококк (экстракт).
- Эхинацея (цветы).
- Шиповник (цветы, плоды).
- Зверобой (цветы, листья).
- Боярышник (цветы, плоды, корни).
Из вышеперечисленных растений готовят настои (из одного либо нескольких) в пропорции одна столовая ложка на 200 мл воды.
Лечение беременных
При беременности применение антибиотиков крайне нежелательно, но если в форме инфекционного процесса развивается золотистый стафилококк, то их использование необходимо. Иначе заболевание может принять тяжёлые формы и вызвать серьёзные осложнения. Это в полной мере относится и к лечению маленького ребёнка.
У беременных лечение инфекции стафилококка предусматривает стандартный набор процедур и мероприятий, направленных на уничтожение инфекции и улучшение работы иммунной системы.
Чего нужно избегать
При лечении золотистого стафилококка нужно избегать таких «манипуляций», как:
- Нагревание области носа. При насморке, гнойных выделениях из носа, ни в коем случае, нельзя греть переносицу, области щёк и лба. Особенно, если в этих местах присутствуют болевые ощущения.
- Перегревание организма. Необходимо избегать перегрева, нельзя принимать горячую ванну или душ, посещать баню и сауну.
- Переохлаждение. Переохлаждение также опасно для организма, как и перегрев.
Обратите внимание! Перегрев стимулирует увеличение скорости размножения бактерий, а переохлаждение приводит к ослаблению иммунной системы и соответственно снижению способности сопротивления организма.
Профилактические меры
В большинстве случаев трансформация стафилококка из условно-патогенной в патогенную стадию связана с иммунитетом, который находится в угнетённом состоянии.
В этой ситуации при профилактике заболевания имеют принципиальное значение следующие факторы:
- Здоровый образ жизни, занятия спортом.
- Правильное, сбалансированное питание, в рацион которого должны быть включены фрукты и овощи на протяжении всего года.
- Лечение в обязательном порядке респираторных заболеваний противовирусными медикаментами.
- Обеспечение приёма препаратов, стимулирующих иммунитет, для профилактики. Делается это в сезон, когда вирусные инфекции обостряются, то есть поздней осенью и в начале зимы.
- Непременное лечение герпеса – простуды на губах. Многие не придают большого значения так называемой простуде на губах, причём напрасно. Этот вид герпеса приводит к развитию специфического вида иммунодефицита.
- Поддержка организма витаминными комплексами (один курс каждые полгода).
А также следует соблюдать базовые гигиенические правила:
- Тщательное мытьё рук с мылом.
- Термическая обработка мяса и рыбы.
- Поддержание порядка в жилом помещении, регулярное проветривание жилища, влажная уборка.
mama.guru
Золотистый стафилококк в носу у ребёнка: симптомы и лечение
Стафилококки – очень распространенный вид бактерий. Живут эти микробы везде – на коже, слизистой, в организме людей и животных, на предметах быта и продуктах питания. Их не уничтожают даже самые агрессивные погодные условия. После замораживания или засушивания стафилококки могут дальше функционировать, когда условия улучшатся. Впервые узнав эту информацию можно ужаснуться, но на самом деле их присутствие не так страшно, как кажется.
Что такое золотистый стафилококк
Только 5% взрослых людей не заражены стафилококком. У остальных либо он есть в хронической форме, либо появляется периодически. Нормальный иммунитет здорового человека способен подавлять размножение этих микроорганизмов. Даже дети, с самого рождения контактирующие с данными бактериями, живут без какой-либо симптоматики и вреда для здоровья. Однако при снижении иммунитета или изначально ослабленном организме новорождённого, рост количества бактерий может переходить допустимые нормы. В таком случае это считается заболеванием, которое необходимо лечить.
Симптомы стафилококка в носу у детей
Детский организм тяжелее переносит влияние вредоносных бактерий, чем взрослый. Поэтому у ребёнка такое несложное заболевание может быстро перерасти в серьёзную проблему. Чтобы выявить его, нужно обратить внимание на такие признаки:- насморк;
- большое количество выделений из носа, сначала прозрачных, после гнойных;
- проблемы с дыханием и обонянием как следствие забитости носа;
- хриплость или гнусавость голоса;
- дыхание через рот;
- повышение температуры тела до 38 градусов;
- зуд в носу;
- боли в горле, покраснения слизистых;
- язвы возле носа и губ;
- увеличенные миндалины;
- появление сыпи на теле;
- бессонница;
- усталость;
- боль в голове.
Вышеупомянутые проявления можно наблюдать, если иммунитет хотя бы относительно справляется с болезнью. Разумеется, помочь бороться организму необходимо, но подобная симптоматика не так страшна, как более серьёзные осложнения.
Какие бывают осложнения
Иногда осложнения происходят при долгом течении заболевания и отсутствии правильного лечения. Однако в некоторых случаях стафилококк в носу у ребёнка мгновенно вызывает такие симптомы:
- резкое повышение температуры выше 39 градусов;
- так же внезапно температура падает до 37-38 градусов;
- тошнота, рвота;
- диарея, вздутие живота;
- плохой аппетит или его отсутствие;
- слабость;
- воспаление гортани и нижних дыхательных путей.
В особо тяжёлых случаях стафилококковая инфекция вызывает:
атрофию слизистой оболочки носа;- воспаление легочной ткани с гнойно-некротическим поражением;
- скопление гноя в плевральной полости;
- менингит;
- воспаление почек;
- судороги;
- сердечные заболевания;
- воспаление брюшной полости;
- заражение крови.
Золотистый стафилококк в носу у ребёнка может нанести огромный ущерб всему организму ребёнка. Причина в том, что детский организм не успевает подавить размножение микроорганизмов – они мгновенно распространяются не только по носоглотке, но и по всему телу. Попадая в кровь, стафилококк поражает многие органы и выделяет токсины, которые разрушают клетки.
Токсины в организме у детей вызывают более выраженную симптоматику, так как маленький организм получает сильное отравление ими.
Причины и пути заражения
Как уже было сказано, данные микроорганизмы есть везде, потому вариантов, как ими можно заразиться, масса. Они легко передаются бытовым, воздушно-капельным, воздушно-пылевым путями. Мать может передать стафилококк во время беременности, родов или кормления грудью.
Чтобы бактерии не поступали в организм в больших количествах, стоит придерживаться гигиенических норм, разнообразить питание ребёнка, правильно обрабатывать продукты, избегать потенциальных аллергенов в детской комнате и приучать ребёнка к активному образу жизни. Однако учитывая распространённость микроорганизма, стоит обратить внимание на причины, по которым он поражает один организм и не вредит другому.
- Недоношенность. У недоношенных детей много проблем с иммунитетом, а потому есть опасность заразиться различными микробами.
- Отсутствие молока у матери. Молоко матери помогает усилить иммунную систему ребёнка. Если по каким-либо причинам мать не может кормить ребёнка грудью, его иммунитет развивается хуже.
- Заболевание иммунной системы. Дети, больные ВИЧ, подвержены риску заражения стафилококком.
Как диагностируют золотистый стафилококк
Чтобы узнать, какие именно микроорганизмы стали причиной заболевания, врач берёт мазок из носа и анализ кала для лабораторного исследования. Данные способы не только помогают определиться с диагнозом, но и корректируют лечение заболевания. С помощью взятого материала специалист может выяснить, к какому лекарству бактерия более чувствительна.В случае осложнений в органах у ребёнка педиатр может назначить дополнительные методы изучения состояния организма: рентген носа, УЗИ внутренних органов, анализ крови и мочи.
Чем лечить стафилококк в носу у ребёнка
Для того чтобы лечение стафилококка в носу у ребёнка было эффективным, назначают комплекс препаратов – антибиотики, антигистаминные препараты, иммуномодуляторы, витамины, жидкости для обработки носовой полости. Если у заболевания есть осложнения, список препаратов увеличивается – сбивается повышенная температура, прописываются препараты для поддержки печени или другого пострадавшего от болезни органа.
Из антибиотиков хорошо помогают вылечить стафилококк:
- Амоксиклав;
- Цефтриаксон;
- Офлоксацин;
- Манкомицин;
- Оксациклин;
- Уназин.
Важно, чтобы врач правильно подобрал дозировку антибиотика. Одна из самых распространённых ошибок самолечения – неправильное использование препарата. Если пить антибиотик в недостаточном количестве или пропускать приём препарата – микроорганизм приспособится к лечению. В таком случае антибиотик приходится сменять на другой, а резкая смена препаратов добавляет ослабленному организму вреда. Также антибиотики приходится сменять, если улучшение не наступает даже при правильном приёме препаратов. Курс лечения при данной инфекции долгий – от двух до трёх недель.
Среди иммуномодуляторов и иммуностимуляторов наиболее часто назначают:
Иммунал;- Иммунорикс;
- Полудан;
- Тактивин.
Антибиотик убирает первоначальную проблему, а иммуномодулятор должен помочь иммунитету в дальнейшем справляться с инфекцией. Без использования данных средств лечение может давать кратковременный эффект.
Витамины также важны для лечения. Даже те дети, которые хорошо питаются, могут испытывать недостаток витаминов и минералов в период болезни. Организму, чтобы бороться с заболеванием, нужно повышенное количество полезных веществ. Некоторые витамины усиливают иммунную функцию организма.
Промывать нос рекомендуется Хлоргексидином, Мирамистином, солевым раствором, Хлорофиллиптом.
Снаружи язвы и гнойнички можно обрабатывать зелёнкой. Внутри носа их можно мазать тетрациклиновой мазью. Обработка спиртом или перекисью не даёт необходимого эффекта. Язвы категорически нельзя чесать. В случае если абсцессы крупные, иногда необходимо хирургическое вмешательство, чтобы их вылечить.
Также в лечении стафилококка хорошо помогает стафилококковый бактериофаг. Это биопрепарат, содержащий в составе полезные вирусы, которые действуют на болезнетворные микроорганизмы.
Народные методы лечения
В качестве дополнительного лечения можно использовать такие народные способы:
Эфирные масла. Хорошо подходят для обработки кожи: можжевеловое, пихтовое, кедровое, эвкалиптовое и масло чайного дерева. Наносить их на открытые ранки категорически нельзя, только рядом с раной или на почти зажившие. Перед активным использованием желательно проверить кожу на чувствительность и отсутствие аллергии. Для этого стоит нанести совсем немного масла и подождать некоторое время. Если нет сильного покраснения, зуда и жжения – эфирное масло можно использовать. Есть и другой способ использования эфирных масел – распыление их в комнате с помощью аромалампы. Это не только поможет дезинфицировать кожу, но и уничтожит бактерии в комнате.- Отвары из трав. Их употребляют внутрь, обрабатывают ранки или промывают носовую полость. Отвар ромашки универсален и подойдёт для всех этих методов лечения. Шиповник, липу, малину пьют, чтобы повысить иммунитет.
- Белая глина. Эту горную породу используют для обработки гнойничков. Её как мазь наносят на проблемную часть кожи.
Нежелательно применять народные средства в качестве основного лечения. Они хорошо помогают в сочетании с лекарствами традиционной медицины, но без антибиотиков и иммуностимуляторов могут быть бессильны перед тяжёлой стафилококковой инфекцией. Из-за времени, потраченного на неэффективное лечение, в организме ребёнка могут начаться осложнения.
pulmono.ru
Симптомы и лечение золотистого стафилококка в носу и горле у ребенка
Стафилококк в носу у ребенка очень распространенное инфекционное заболевание, которое с каждым годом встречается все чаще. Хорошей новостью является то, что наука уже хорошо изучила стафилококк и легко справляется с проявлениями инфекции у детей и их родителей.
Особенности стафилококовой инфекции и пути передачи
— это очень устойчивая и живучая бактерия, она может сохранять свои способности и инфицировать человека даже в условиях благоприятной среды. Бактерии не погибают под воздействием солнечных лучей и низких температур. В условиях засухи могут жить до 8 месяцев. Стафилококк способен выдерживать нагревание до 70°С. Однако при всей своей устойчивости он погибает от банального кипячения. Обрабатывая продуты кипятком, человек обезопасит себя от этой инфекции. Стафилококк чувствителен к зеленке, если обработать ею порез, то вполне можно избежать заражения. Конечно, в случае с инфекцией, которая развилась в носу, зеленка не поможет, здесь нужны препараты посерьезней.
Патологические процессы вызывает золотистый стафилококк в носу, он также может паразитировать на слизистой оболочке горла у новорожденных. Запущенный золотистый стафилококк в горле и носу может спровоцировать такие заболевания, как:
- острый и хронический тонзиллит;
- отит;
- гайморит;
- менингит;
- септический артрит;
- внутричерепной флебит;
- эндокардит;
- гнойную фолликулярную ангину;
- пневмонию;
- стафилококковый сепсис и ряд других неприятных болезней.

Хотелось бы отметить, что стафилококк — это условно патогенный микроорганизм, в небольшом количестве бактерии не приносят вреда человеческому организму. Как говорит статистика, 70% населения заражены стафилококковой инфекцией. Лечение нужно начинать, когда золотистый стафилококк становится причиной хронических или реципирующих воспалительных процессов в организме. Определенное количество инфекции находится у большинства людей, как уже выше упоминалось, но активизируется бактерия только под воздействием определенных факторов, таких, к примеру, как снижение , эмоциональные потрясения, недостаток витаминов или респираторные вирусные заболевания.
Стафилококк в горле у ребенка или в носу может появиться несколькими способами:
- контактный способ передачи;
- воздушно-капельный путь;
- во время кормления грудным молоком;
- через плаценту во время родов;
- вследствие недостаточной обработки продуктов питания.
Путей заражения, как видно из вышеперечисленных фактов, много, поэтому не стоит беспечно относиться к этой болезни и игнорировать ее симптомы.
Симптоматика стафилококковой инфекции
Стафилококк у детей в носу симптомы имеет ярко выраженные, среди них можно отметить:
- темно-зеленые выделения из носа, длительный ринит;
- покраснение кожи вокруг носа;
- нарушение обоняния;
- изменения голоса;
- зуд и дискомфорт в носу;
- головная боль;
- повышение температуры тела;
- появление гнойников, если стафилококк обитает в горле;
- нарушения функциональности желудочно-кишечного тракта, что проявляются в поносе, запоре и тошноте;
- у гиперчувствительных детей стафилококковая инфекция сопровождается сыпью на коже;
- боль в животе, возможны кишечные ;
- снижение артериального давления;
- общая слабость и интоксикация организма.

Интенсивнее всего симптомы проявляются у новорожденных, так как их организм еще не успел адаптироваться к воздействию внешней среды. Грудничок, подхвативший эпидермальный стафилококк, плохо спит, теряет аппетит, очень капризен. Часто родители путают подобное состояние детей с кишечными коликами или признаками резки зубов, этим усложняя ситуацию. Если родитель замечает подобные признаки, лучше посетить врача, который точно поставит диагноз. Гораздо разумнее перестраховаться и исключить стафилококковый ринит или тонзиллит, чем потом бороться с его последствием.
Диагностика стафилококка
Для того чтобы начать лечение, изначально требуется диагностика. Множество врачей не перестают утверждать, что правильно поставленный диагноз — залог эффективного и быстрого выздоровления. Первым делом доктор на основе жалоб пациента или его родителей проведет визуальный осмотр кожных покровов. Анализом, с помощью которого в большинстве случаев диагностируют присутствие инфекции, является бакпосев на питательную среду. У ребенка берут мазок из носа или из горла, если есть подозрение на его место локации в этом отделе организма. Очень важно подготовить ребенка. Перед сдачей мазка утром нельзя кушать и пить чай, не следует пользоваться зубной пастой и полоскать горло. Эти, на первый взгляд, ни с чем не связаные процедуры могут сказаться на достоверности анализа. До сдачи анализа не следует употреблять лекарства, если их отменить нельзя, нужно сообщить об этом врачу.
Принципы лечения стафилококка в носу
Как лечить стафилококк, знают немногие, поэтому, услышав диагноз, начинают паниковать, но делать этого не стоит. Современная фармакология предлагает огромное количество препаратов, чувствительных к этой инфекции. Важно отметить, что препарат должен назначать только лечащий врач. Самостоятельно назначать ребенку медикаменты запрещено. Не стоит прислушиваться и к советам знакомых и соседей, которые сталкивались с подобными диагнозами, ведь те средства, что вылечили их, могут навредить вашему малышу.

После детальной диагностики доктор должен решить, как именно будет проходить лечение, и будут применяться антибактериальные или сульфаниламидные лекарства. Подбор медикаментозных средств проводится в индивидуальном порядке с учетом возраста пациента, массы его тела и других особенностей его организма. Чаще всего для устранения стафилококковой инфекции из носа и горла выбирают такие средства, как:
- Флемоклав;
- Анкомицин;
- Оксациллин;
- Амоксиклав;
- Ванкомицин;
- Уназин;
- Клиндамицин;
- Эритромицин;
- Азитромицин;
- Цефалотин;
- Цефалексин.
Лечение можно проводить местными средствами, к примеру, промывать нос, используя солевые растворы Мирамистин или Хлоргексидин. Отличным решением будут и , такие как:
- Полидекса;
- Изофра;
- Хлорофиллипт;
- Протаргол.
Если заложенность носа отмечается очень сильная, то рекомендован прием сосудорасширяющих капель.
Снять гнойничковые поражения слизистой оболочки носа помогут тетрациклиновая и эритромициновая мази. Если гнойники больших размеров, то врач будет их вскрывать и обрабатывать антисептическими средствами. Самостоятельно их удалять нельзя. Дело в том что жидкость, содержащаяся в гнойничке, как раз и является источником стафилококковой инфекции, если она попадет на здоровые участки кожи, то может поразить и их. При стафилококковой инфекции в горле назначают частые полоскания перекисью водорода, Фурацилином, Мирамистином.
Лечение будет включать и общеукрепляющие средства, так как требуется комплексный подход для устранения патогенных бактерий. Среди таких препаратов можно отметить:
- Тактивин;
- Иммунорикс;
- Полудан;
- Иммудон;
- Супрадин;
- Алфавит;
- Витрум.

Использование укрепляющих средств позволяет повысить иммунитет пациента, ведь как известно, организм с устойчивым иммунитетом лучше справляется с патогенными процессами. Для ускорения действия антибиотиков и других лекарств требуется употреблять в пищу больше продуктов, содержащих витамины и полезные микро- и макроэлементы. Также нужно попытаться снизить физическую активность ребенка, пускай больше отдыхает.
Если имеет место отечность крыльев носа и кожная сыпь, то требуется провести лечение антигистаминными средствами, такими как:
- Тавегил;
- Диазолин;
- Зиртек.
Если наблюдаются побочные эффекты от вышеуказанных препаратов или же они не дают результата, то необходимо сообщить об этом врачу, и он заменит схему лечения.
Длительность лечения, дозировку препарата в индивидуальном порядке назначает врач. Перед использованием средства не лишним будет прочесть инструкцию и исключить возможные противопоказания применения.
Средства народной медицины
Стафилококкус ауреус можно устранять и народными методами лечения. Конечно, предпочтение в первую очередь нужно отдавать традиционным способам, но есть ряд случаев, когда обратиться за квалифицированной помощью нет возможности, тогда на помощь придут и домашние рецепты.
Из сухих цветков ромашки готовят отвар, настаивают полчаса, а дальше закапывают в нос. Ромашка — всем известное противовоспалительное и антисептическое средство, поэтому ее использование вполне оправданно.
Траву сушеной травы шалфея готовят по тому же способу, что и ромашку, но отваром полоскают горло при наличии гнойничков.
Корень лопуха измельчают и смешивают с небольшим количеством кипяченой воды. Сок с водой, что получился, закапывают в нос по 5 капель каждые 3 часа.

Для полоскания горла используют спиртовую настойку прополиса, разведенную в кипяченой воде. Она позволяет удалить гнойничковую сыпь и облегчить глотание при воспаленном горле.
Для устранения стафилококка применяют компрессы. Для этого используют обычны ватный тампон, смоченный в воде, разведенной с яблочным уксусом. Подобные примочки делают к каждой ноздре по полчаса. Как утверждают люди, тестировавшие средство, эффект будет заметен уже через три применения.
Очень хорошо себя проявило такое растение, как алоэ, сок из этого растения не только повышает иммунитет, но и удаляет стафилококковую инфекцию. Нужно закапывать сок из свежих листьев растения 3 раза в день. Важно отметить, что это дает результат очень быстро,так как алоэ провоцирует приступ чихания у ребенка. Зеленые сгустки, которые мешают дышать ребенку, очень быстро выходят наружу.
Не стоит увлекаться народной медициной, и если она не дает результат, то лучше прекратить использовать старинные рецепты лечения. Иногда они могут только ухудшить самочувствие ребенка и спровоцировать ряд осложнений, бороться с которыми будет сложнее, чем лечить саму инфекцию.
Лучший эффект достигается, когда традиционная медицина комбинируется с народной. В подобном случае в качестве основного лечения идут синтетические препараты, а в качестве дополнения общеукрепляющие средства на натуральной основе, как советует народная медицина.
Профилактика стафилококка и дополнительные рекомендации
Категорически запрещено прогревать нос или использовать горячие ванны для прогревания тела. Если воздействовать теплом на больной организм, то стафилококк начинает размножаться еще быстрее, поражая новые участки, ведь создаются благоприятные условия для его жизнедеятельности. Не стоит использовать такие народные средства, которые включают мед, сладкие фруктовые соки, молочные продукты, они тоже провоцируют размножение стафилококка.

Не стоит вставлять ребенку тампоны, смоченные в спирту, как советуют псевдоцилители. Бактерии этой группы вовсе не чувствительны к спирту, подобным лечением вы только будете раздражать слизистую оболочку и приведете к сухости носа и жжению.
Как и любую болезнь, стафилококковую инфекцию легче предупредить, чем бороться с ее последствиями. В качестве профилактики можно посоветовать:
- постоянно следить за гигиеной рук ребенка;
- давать еду только из чистой посуды;
- тщательно обрабатывать пищу перед готовкой;
- регулярно проводить влажную уборку в доме;
- постоянно укреплять иммунитет;
- увлажнять воздух, проводить проветривания в помещениях, где находится ребенок;
- избегать контактов с больными людьми.
Придерживаясь таких простых профилактических мероприятий, удастся оградить малыша от воздействия бактерий и развития неприятных заболеваний.
kidfeed.ru
Золотистый стафилококк в носу у ребенка, у детей
Золотистые стафилококки – это патогенные бактерии, которые спокойно живут на слизистых оболочках и дерме человека. Если никаких провоцирующих факторов не возникает, то они не дают о себе знать. Так как эти бактерии патогенные, то они способны синтезировать особые токсины и ферменты. Они наносят разрушающее действие на жизнедеятельность клеток.
Затормозить активное распространение и развитие этих микроорганизмов под силу только сильному иммунитету. Если же защитные силы организма дали сбой, то золотистый стафилококк переходит в атаку и приводит к развитию патологического процесса на слизистой в носу.
Симптоматика
Золотистый стафилококк у ребенка может поразить даже слизистые носа. Распространение инфекции возможно даже в малом количестве. Причем концентрация бактерий повышается с каждым днем.
Для рассматриваемого патологического процесса свойственны следующие симптомы:
- ощущение зуда в носу и сопельные выделения;
- секрет выделяется в избыточном количестве;
- герпес около носа и на губах;
- общая усталость и вялость;
- скачки температуры тела;
- головная боль;
- сложное дыхание по причине заложенности носа;
- увеличение аденоидной оболочки;
- формирование насморка;
- поражение горла и покраснение его;
- увеличение миндалин.
Определенные признаки могут возникнуть единично, а некоторые из них отсутствуют вообще. Клиническая картина у ребенка выступает в качестве защитной реакции организма. Причем общее самочувствие маленького пациента заметно ухудшается. Золотистый стафилококк действует пассивно, но на протяжении долгого времени. Чтобы лечение стафилококка в горле и носу было составлено правильно потребуется тщательная диагностика.
На видео- чем опасен золотистый стафилококк в носу у ребенка:
Медицинское лечение
Сегодня имеется множество способов терапии, направленных на борьбу с золотистым стафилококком. Назначить тот или иной препарат ребенку сможет только врач. Здесь он руководствуется тяжестью патологического процесса и возрастом пациента.
Антибиотики
Эти препараты врач назначает на начальном этапе развития патологии. Благодаря им удается нейтрализовать патогенные микробы и облегчить состояние больного. На некоторые антибиотики у золотистого стафилококка выработался иммунитет. Но есть ряд медикаментов, которые успешно борются с бактериями в носу у ребенка:
- Цетриаксон,

Цетриаксон
- Азитромицин (а вот как стоит использовать Азитромицин при гайморите, поможет понять данная статья)

Азитромицин в капсулах
- Амоксиклам,

Амоксиклам
- Ванкомицин.
При приеме подобных лекарств стоит понимать, что они имеют ряд побочных эффектов, так что ребенок должен принимать их с большой осторожностью. Кроме этого, в комбинации с антибиотиками малышу должны назначить биопрепараты, благодаря которым удается поддержать микрофлору ЖКТ.
А вот можно ли Тонзилгон при беременности и как правильно его использовать, поможет понять данная статья.
Почему постоянно свербит в носу и какими средствами, в том числе и лекарственными можно избавиться от данной проблемы, поможет понять данная статья.
Что делать, если не проходит насморк и заложенность носа и как быстро избавиться от такой проблемы, рассказывается в данной статье: https://prolor.ru/n/lechenie-n/ne-proxodit-zalozhennost-nosa-chto-delat.html
А вот как лечить отек слизистой носа и какие средства можно использовать в домашних условиях. рассказывается в данной статье.
Стафилококковый бактериофаг
Этот препарат можно задействовать только при условии, то был диагностирован золотистый стафилококк в носу, но осложнения при этом отсутствуют. Общая продолжительность применения составит 21 день. После лечения ребенок снова должен сдать анализы. Если они положительные, то врач назначает восстановительную терапию.
Лекарства на основе морской соли
Купить их сегодня можно в любой аптеке. Причем следите, чтобы в его составе присутствовала именно морская соль. Она эффективно влияет на бактерии, а еще удаляет избыток сопельного секрета. Самыми эффективными остаются такие лекарства Акввмарис, Долфин (а вот как промывать нос ребенку Долфином, рассказывается в данной статье).

Хлорофиллипт
Этот препарат показал высокую результативность при лечении золотистого стафилококка. В его составе содержатся такие активные компоненты, как экстракты хлорофиллов а и b, полученные из эвкалипта. Продается лекарство в виде масляной или спиртовой настойки, а также имеется таблетированный препарат.

Хлорофиллипт
Для Хлорофиллипта характерен узкий спектр влияния, а еще он способен купировать все стафилококки. Если у ребенка есть непереносимость эфира эвкалипта, то подобное лечение может стать причиной развития аллергии кожи, отека слизистых лица и носоглотки. А вот как использовать Хлорофиллипт при ангине, поможет понять данная статья.
Зеленка
И хотя золотистый стафилококк проявляет повышенную устойчивость к сильным антибиотикам, он восприимчив к обычной зеленке. При наличии гнойников зеленый бриллиант можно задействовать для обработки поражённых участков.
Мази
При лечении стафилококка в носу у ребенка врач может назначить мази. Если рассматривать самую современную и эффективную мазь, то это Бактробан. В ее составе имеется такой эффективный компонент, как антибиотик мупироцин.

Бактробан
Он обладает локальным влиянием на бактерии. Использовать мазь можно для поверхностной обработки носовых ходов или делать ватные тампоны. Проводить такие мероприятия 2 раза в день.
А вот как очистить носоглотку от хронической слизи, и какие средства лучше всего использовать, рассказывается в данной статье.
Почему возникают в носу корки и болячки и какими мазями стоит пользоваться, рассказывается в данной статье.
Народные средства
Нетрадиционные варианты терапии золотистого стафилококка в носу у ребенка необходимо задействовать только в сочетании с основным лечением. Бактерии чувствительны к различным травам и растениям, среди которых шалфей, подорожник, эхинацея и лопух. Если наблюдается серьезное заболевание, то одно растение справиться с ним будет не в состоянии. В таком случае нужно использовать сложные, многокомпонентные отвары.
Эффективными остаются такие рецепты:
- Сок корня петрушки и сельдерея. Полученное лекарство стоит принимать деткам при хронической форме стафилококкового заболевания. Необходимо взять корень сельдерея и корень петрушки в пропорции 1:2. Мелко нарубить, выдавить сок и вести прием по 10 мл за 40 минут до еды.

Сок корня петрушки и сельдерея
- Корень лопуха и окопника. На основании этих растений модно поучить эффективный настой для полоскания. Корни мелко нарубить, соединить в равном количестве и на 20 г сырья добавить 200 мл кипятка. Через полчаса отфильтрованный и теплый настой применять для промывания.
- Лопух и эхинацея. Необходимо взять 20 г корня эхинацеи, 20 г корня лопуха. Добавить 1 л кипятка. Томить на огне около 20 минут. Отфильтровать и принимать по 20 мл 3 раза в сутки. Пить лекарство на протяжении 3 дней. Противопоказано детям до 3 лет.
Золотистый стафилококк в носу у ребенка способствует развитию многочисленных заболеваний дыхательных путей. Если не приступить к их своевременному лечению, то состояние маленького пациента резко ухудшиться, ведь патологический процесс ведет за собой развитие ряда осложнений. Терапия обязательно должна быть комплексной, ведь нужно устранить бактерии, облегчить симптомы и повысить иммунитет.
prolor.ru
лечение у ребенка и взрослого
Золотистый стафилококк (Staphylococcus aureus) – это условно-патогенные бактерии, которые живут в носу у многих людей. Специалисты называют золотистый стафилококк метициллин-резистентным (MRSA), так как бактерии успели приобрести невосприимчивость к антибиотикам. Золотистый стафилококк в носу – широко распространенное явление. Его можно обнаружить на слизистых оболочках 75% людей. Микроб не причиняет вреда до тех пор, пока у человека сильный иммунитет.
Иммунитет здорового, физически крепкого человека легко справляется с этой бактерией, но после приема антибиотиков, гриппа и других вирусных болезней, сильного переохлаждения иммунитет снижается, а стафилококки активизируются и становятся опасными.

СодержаниеПоказать
Как бактерия попадает в нос – способы заражения
загрузка…
Ауреус может обитать на различных участках человеческого тела: в зеве, в промежности, в подмышках, в прямой кишке. Заражение золотистым стафилококком происходит в основном контактно-бытовым путем. Бактерии переходят от человека к человеку при непосредственном контакте: через рукопожатия и другие виды прикосновений.
Стафилококки способны долго выживать в окружающей среде, поэтому передаются через предметы быта, постельное белье, одежду. Особенно много микробов обнаруживается в сухой домашней пыли.
Эпидемиологи подразделяют людей на три группы:
- носители золотистого стафилококка, из зева которых в любое время можно выделить культуру этой бактерии;
- неинфицированные люди – золотистый стафилококк в носу отсутствует;
- переменные носители – бактерии можно выделить только в отдельные периоды времени.
В человеческой популяции постоянными носителями стафилококка являются 20 % людей. Их невозможно вылечить от инфекции. Еще 20% никогда не бывают носителями этих бактерий. Остальные 60% населения – переменные носители.

Некоторые категории населения заражены стафилококком практически на 100%: больные СПИДом, носители вируса иммунодефицита, инсулинозависимые диабетики, пациенты, проходящие курс гемодиализа, дерматологические больные.
Согласно исследованиям, 8% людей, поступающих в стационар, уже инфицированы золотистым стафилококком. Они представляют опасность для других пациентов и для себя, поскольку у заболевшего человека бактерии активизируются.
Микроб передается следующими путями:
- аспирационным;
- контактным;
- фекально-оральным;
- вертикальным – от матери к плоду.
Роль воздушно-капельного пути возрастает во время эпидемий гриппа и ОРВИ.
Источником золотистого стафилококка могут быть домашние животные. Особенно часто возбудитель обнаруживается у собак и лошадей.
Заразиться золотистым стафилококком можно после медицинских манипуляций. Бактерии передаются через медицинские инструменты и контактным путем – через руки медперсонала. Источником заражения может стать медицинская аппаратура, перевязочный материал и даже кнопки лифта в больнице. Доказаны случаи распространения золотистого стафилококка через стетоскопы, импланты, аппараты искусственного вентилирования легких, фото и другие бумажные носители, телефоны и персональные компьютеры.

Чем опасна активизация стафилококка?
Активизировавшись, MRSA способен стать причиной серьезных заболеваний, угрожающих жизни:
- воспаления легких;
- сепсиса;
- токсического шока.
Осложнения стафилококковой инфекции заметно влияют на медицинскую статистику: увеличивают процент летальности в медицинских стационарах и среднюю продолжительность пребывания пациентов в больнице.
Существует много видов стафилококков, из них золотистый наиболее опасен. Пациенты, инфицированные золотистым стафилококком, умирают в стационарах втрое чаще, чем люди со стафилококковой инфекцией, вызванной видами, чувствительными к антибиотикам.

Симптомы инфекции
Что говорят врачи о паразитах
Доктор медицинских наук, профессор Гандельман Г. Ш.:
Занимаюсь обнаружением и лечением паразитов уже много лет. С уверенностью могу сказать, что паразитами заражены практически все. Просто большинство из них крайне трудно обнаружимы. Они могут быть где угодно — в крови, кишечнике, легких, сердце, мозге. Паразиты в буквальном смысле пожирают вас изнутри, заодно отравляя организм. В итоге, появляются многочисленные проблемы со здоровьем, сокращающие жизнь на 15-25 лет.
Основная ошибка — затягивание! Чем раньше начать выводить паразитов, тем лучше. Если же говорить о лекарствах, то тут всё проблематично. На сегодняшний день существует только один действительно эффективный антипаразитный комплекс, это Toximin. Он уничтожает и выметает из организма всех известных паразитов — от головного мозга и сердца до печени и кишечника. На такое не способен больше ни один из существующих сегодня препаратов.
В рамках Федеральной программы, при подаче заявки до 12 октября. (включительно) каждый житель РФ и СНГ может получить одну упаковку Toximin БЕСПЛАТНО!
Активизация MRSA в носоглотке вызывает скопление слизи на задней стенке зева. Больной вынужден постоянно отхаркиваться. Во рту появляется неприятный запах.
Чем опасен активировавшийся стафилококк?
Он способен вызвать следующие заболевания носа и горла:
- Хронический ринит – патология, при которой из носа постоянно выделяется слизь.
- Хронический синусит – воспаление носовых пазух. Сопровождается выделениями из носа и болевыми ощущениями в области переносицы, кашлем.
- Хронический аденоидит – патологическое увеличение носоглоточной миндалины, способное привести к серьезным поражениям почек, сердца, пищеварительного тракта и суставов.
- Хронический тонзиллит – длительное воспаление миндалин

Диагностика
загрузка…
Для обнаружения золотистого стафилококка используют микроскопическое исследование. Для микроскопирования берут отделяемое носоглотки или мокроту.
Забор биоматериала проводит медработник. Процедура выполняется с соблюдением правил асептики. Биоматериал переносится в чашку Петри на кровяной агар и помещается на 24-48 часов в термостат, где поддерживается температура +35…+37°C.
Из образовавшейся колонии микроорганизмов делают мазок, окрашивают по Грамму и микроскопируют. Чтобы отличить золотистый стафилококк от других видов проводят несколько дополнительных тестов. Выявив стафилококк, обязательно проводят определение его чувствительности к антибиотикам.
загрузка…
У пациентов с подавленным иммунитетом для обнаружения стафилококка используют молекулярно-генетические методы.
Методы лечения
Антибактериальная терапия помогает избавиться от бактерий в носоглотке. Препараты для лечения выпускаются в форме мазей, спреев и растворов. Одновременно с лекарственной терапией нужно соблюдать санитарно-гигиенические меры: каждый день менять постельное белье и одежду, стирать одежду при температуре более +60°C.
Обычно терапевтический курс длится не более 10 дней и завершается контрольными пробами на 7, 14 и 21 день, а затем через 3, 6 и 12 месяцев. Если контрольная проверка выявит MRSA, лечение придется повторить.
Лекарственные средства
Основная сложность в терапии золотистого стафилококка в том, что эти бактерии не чувствительны к антибиотикам – об этом предупреждает родителей известный педиатр, доктор Комаровский.
Для лечения детей и взрослых используют дезинфицирующие растворы или препараты на основе фагов, представляющие собой медицинские средства последнего поколения, убивающие бактерии с помощью особых вирусов.
Самый самые популярные способ лечения стафилококковой инфекции заключается в использовании иммуномодуляторов и лизатов бактерий. Эти препараты действует подобно прививкам. Они содержат частички убитых бактерий и усиливают выработку антител к определенным группам микроорганизмов, в том числе к золотистому стафилококку.
Таблица 1. Противостафилококковые препараты
Препарат | Способ применения |
Спиртовой раствор Хлорофиллипта однопроцентный или масляный раствор Хлорофиллипта двухпроцентный | Полоскают зев три-четыре раза в день, курс 7-10 дней. Для обеззараживания носа масляный раствор вводят в ноздри трижды в день по 3-4 капли, курс неделя. |
| Стафилококковый бактериофаг, раствор для полоскания | Полоскают зев 3-4 раза в день, курс неделя. В нос закладывают на 15-20 минут шарики из ваты, смоченные в бактериофаге. |
| ИРС 19 | Спрей, содержит фрагменты стрептококка и золотистого стафилококка. Лекарство можно использовать для предупреждения носоглоточных инфекций у взрослых и детишек, начиная с трехмесячного возраста. Спрей впрыскивают в обе ноздри 2-4 раза в день, курс 8-10 дней. Для профилактики делают 2 ежедневных впрыскивания в течение месяца. |
| Бронхо-Мунал | Бактериальный иммуномодулятор, выпускается в виде раствора для перорального применения. Принимают натощак с утра по одной капсуле на протяжении 10-30 дней. Назначают взрослым. У ребенка можно применять с 6 месяцев. |
| Имудон | Противовоспалительный противоинфекционный препарат, стимулирующий иммунитет. Назначают подросткам и детям старше 3 лет. Дозировка – 8 таблеток в сутки через каждые два-три часа, курс лечения 10 дней. Для профилактики – 6 таблеток в сутки через каждые 3-4 часа, курс лечения 20 дней. |
| Бактробан | Мазь для смазки тампонов. Действующее вещество мупироцин – антибиотик, эффективный против стафилококков и стрептококков. Тампон вводится в нос на 15-20 минут дважды в день, курс 5 дней. Подходит для взрослых и детей с 12 лет. |
Примечание. Не рекомендуется одновременно использовать бактериофаг и спиртовые капли в нос Хлорофиллипт. Спирт убьет фагов и дорогой препарат потеряет эффективность.
Народные методы
Золотистый стафилококк нечувствителен к самым сильным антибиотикам, но он погибает даже в слабом растворе любого анилинового красителя. Самый популярный анилиновый краситель в домашних аптечках – обычная зеленка.
Порезав кожу, нужно не забыть обработать рану раствором бриллиантового зеленого – это предупредит появление нагноения, вызванного стафилококками и другими микроорганизмами.
Очистка от стафилококков горла и носовых ходов с помощью зеленки не практикуется, так как препарат обжигает слизистые и небезопасен при попадании в желудочно-кишечный тракт. Против поселившегося в носу и горле золотистого стафилококка в народной медицине практикуют другие способы.
Настойка прополиса (пчелиный клей) известна сильными антимикробными свойствами. Она убивает бактерии, подстегивает иммунитет и мобилизует естественные защитные силы организма.

Приготовление:
- Прополис разрезают на маленькие кусочки и заливают спиртом, коньяком или водкой (в воде пчелиный клей не растворяется).
- Переливают в бутылку с темным стеклом и оставляют в прохладном темном месте на 48 часов.
Средство используют для полоскания горла при тонзиллите, синусите, гайморите (если эти заболевания вызваны стафилококковой инфекцией). Взрослые могут не только полоскать горло, но и принимать настойку внутрь по чайной ложке 3 раза в день до еды.
Отвар лекарственных трав – в состав сбора входят растения с иммуномодулирующими, противовоспалительными и дезинфицирующими свойствами: лабазник, хмель, аировый корень, ромашка, мята, душица, кипрей, укропное семя, эхинацея.

Приготовление:
- Отмерить по 2 чайные ложки всех компонентов (травы должны быть в высушенном виде.
- Хорошо перемешать.
- Две столовые ложки смеси трав залить литром кипятка.
- Выдержать в термосе 10 часов.
- Пить по 0,5 стакана 3 раза в день до еды, курс 1-3 месяца.
Настойка из окопника и лопуха, приготовление:
- Сушеные листья лопуха и окопника смешать в равных частях.
- Треть стакана смеси залить литром кипятка, настоять 15 минут.
- Процедить, принимать 3 раза в день по одному стакану.
Продолжительность курса – до выздоровления или облегчения симптомов.

Можно ли уберечься?
Наши читатели пишут
Тема: Во всех бедах виноваты паразиты!
От кого: Людмила П. ([email protected])
Кому: Администрации otparazitoff.ru
Здравствуйте! Меня зовут
Людмила Петровна, хочу высказать свою благодраность Вам и вашему сайту.
Наконец-таки я смогла вылечить сальмонеллез. Веду активный образ жизни, живу и радуюсь каждому моменту!
А вот и моя история
С 45 лет начались проблемы с кишечником и пищеварением, постоянные боли в животе, тошнота, рвота после каждого приема пищи, постоянная диарея, все было очень плохо… Один раз были такие сильные и острые боли в левом подреберье, что даже скорую пришлось вызывать. Чего только не пробовала, больницы, поликлиники, правильное питание, дорогущие лекарства… ничего не помогало.
Так я мучалась почти 15 лет! Все изменилось, когда дочка дала прочитать мне одну статью в интернете. Сначала я ужаснулась, но потом последовала совету, который там написан и не представляете на сколько я за это благодарна. Эта статья буквально вернула мне смысл жизни. Последние 2 года появилась невероятная бодрость, куча энергии, весной и летом каждый день езжу на дачу, выращиваю помидоры и продаю их на рынке. Тетки удивляются, как я все успеваю, откуда столько сил и энергии, все никак не поверят, что мне 62 года.
Кто хочет прожить долгую и энергичную жизнь со здоровой кишечником и нормальным пищеварением при любом питании, уделите 5 минут и прочитайте эту статью.
Перейти к статье>>>Предотвратить инфицирование золотистым стафилококком практически невозможно. Этот микроб обитает повсюду. Особенно много бактерий, не чувствительных к антибиотикам и дезинфицирующим средствам, скапливается в медицинских стационарах. Там они не только не погибают после санобработок помещений, но и демонстрируют умеренный рост. Находясь в больнице, необходимо соблюдать личную гигиену: тщательная мыть руки, немедленно обрабатывать зеленкой раны и царапины и заклеивать их лейкопластырем.
Даже членам семьи нельзя пользоваться в быту одной бритвой или полотенцем. При кашле и чихании нужно закрывать рот платком или согнутым локтем руки, особенно если вы знаете, что являетесь носителем MRSA.
Носители золотистого стафилококка могут трудиться, создавать семьи и вести нормальный образ жизни, социально взаимодействуя с другими людьми. Единственное ограничение – таким людям нельзя работать в медицинских учреждениях, больницах, домах инвалидов.
Итак, золотистый стафилококк – распространенный в природе вид бактерий. Микробы могут находиться на коже человека или в его носоглотке. Большинство населения планеты являются носителями этих микроорганизмов – постоянным или временным. У здорового человека стафилококковая инфекция никак не проявляет себя. При понижении иммунитета микроорганизмы становятся причиной хронических воспалительных заболеваний носоглотки. Если выяснится, что причиной синусита, ринита, тонзиллита или аденоидита является стафилококковая инфекция, врач будет лечить эти заболевания медикаментозно.
Видео от доктора Комаровского о стафилококковых инфекциях:
загрузка…
otparazitoff.ru
симптомы и лечение у ребенка
Многие родители часто сталкиваются с ситуацией, когда заболевание ребенка ринитом или ОРВИ затягивается на длительное время. Стоит отметить, что выявить причину возникновения недуга не всегда просто. Анализы показывают наличие несильного воспаления, внешне ребенок отличается умеренной активностью. Но как правило, наблюдаются симптомы в виде обильных сопельных выделений и гипертрофии аденоидной оболочки. Такое протекание заболевания, происходит, когда появляется стафилококк в носу.
Описание
Перед тем как понять к чему сводится лечение стафилококка в носу, необходимо понять, что представляет из себя эта инфекция. Если говорить научным языком, то это микроорганизмы бактериального происхождения, которые объединяются в группы за счет общей структуры. Фактически золотистый стафилококк в носу представляет собой клеточные анаэробы, который напоминают гроздья винограда. Современная наука различает следующие типы стафилококков:
- Золотистый. Свое название получил из-за характерного окраса. Инфекция чаще всего развивается в носовой полости детей.
- Эпидермальный. Бактерии поселяются на кожном покрове и различных слизистых оболочках.
- Сапрофитный. Эта инфекция активно развивается в системе мочеиспускания и половых органах.
- Гемолитический. Его характерное свойство заключается в попадании в кровеносную систему.
Поскольку речь идет именно о заболеваниях верхних дыхательных путей, то объектом дальнейшего рассмотрения будет золотистый стафилококк. Этот вид был описан в 1884 г. С того времени продолжается активное изучение бактерии. Инфекций обычно заселяется в организм ребенка.
Особенно высока заражаемость стафилококками в медицинских учреждениях. Обычно инфицирование происходит при проведении каких-либо процедур. Вероятность заражения равна 75%. Это происходит, даже когда соблюдаются все правила санитарии и гигиены.

Некоторые врачи сходятся во мнении, что золотистый стафилококк в носу – вполне нормальное явление, которое можно отнести к объекту патогенной микрофлоры. Конечно, отчасти это так, но контролировать инфекцию весьма трудно. При ослаблении иммунитета микроорганизма начинают активно влиять на организм. Поэтому легче проводить профилактику заболеваний, чем их вылечить.
Причины появления
Выше уже говорилось о предположении того, что стафилококки обитают в полости носа постоянно. Основным фактором здесь является состояние иммунной системы. При определении инфекции в носовой полости ребенка, следует учитывать, что ее могут вызвать различные причины. Рассмотрим отдельно каждую из них.
- Передача контактным методом. У ребенка, который посещает детский сад, всегда велика вероятность заразиться бактериями от других детей. Одни малыши являются явными носителями инфекции, которая находится в неактивном состоянии. У других детей ослаблена иммунная функция, и они быстро инфицируются.
- Самозаражение за счет несоблюдения гигиенических правил. Стафилококки – микроорганизмы очень распространенные. Они обитают практически везде. Вероятность заражения повышается, если не мыть руки, грызть ногти, а также облизываться на улице.
- Сниженный иммунитет. Также может стать причиной внезапного инфицирования. Этим и объясняется наиболее частое заражение детей. Также часто воздействию стафилококков подвергаются больные ВИЧ.
Симптомические признаки
Уже упоминалось, что действие микроорганизмов распространяется на верхние дыхательные пути. Инфекция может распространяться даже в малом пространстве. При этом численность бактерий увеличивается с каждым днем. Для золотистого стафилококка характерны следующие симптомы (как у детей, так и взрослых):
- ощущения зуд в носовой полости и первые сопельные выделения;
- избыточные выделения секрета;
- высыпания герпесного типа около носа, а также на губах;
- чувство общей вялости;
- перепады температуры тела;
- мигрени;
- затрудненное дыхание из-за заложенности носа;
- гипертрофия аденоидной оболочки;
- развитие отита;
- распространение заболевания на горло и характерные покраснения в этой области;
- увеличенные миндалины.
Следует отметить, что некоторые симптомы могут проявляться единично, а часть их отсутствовать вообще. Признаки заболевания выступают, как защитная реакция организма. При этом общее состояние ребенка явно ухудшается. Стафилококк может воздействовать пассивно, но в течение длительного времени (несколько лет). Поэтому для организации правильного лечения необходимо провести правильное диагностирование.
Диагностика
При первом осмотре пациента специалист может предположить наличие инфекции, глядя на симптомы больного ребенка. Однако для того чтобы понять, как лечить стафилококк в носу, необходимо точно подтвердить предварительные прогнозы. Наиболее эффективным методом диагностики является мазок на наличие бактерии. Ну и с помощью этой процедуры наличие бактерии определяется лишь спустя некоторое время.
Взятые пробы помещают в специализированные термостаты, где бактерия активно развивается. Посев можно исследовать по истечении недели. При организации процедуры требуется соблюдение стерильности и последовательности взятия анализа. В некоторых случаях из горла ребенка дополнительно берется мокрота для более точного определения инфекции.
Общие симптомы и бактериальный посев не являются единственными способами определения наличия инфекции. Важное место отводится распространенности бактерий по организму. Чтобы исключить переход микроорганизмов в другие системы и органы, больные должны сдать кровь и мочу. Данные процедуры являются обязательными.
О методах лечения
Лечение стафилококка в носу требует комплексного подхода. Не нужно с этим затягивать, и ждать, когда иммунитет сам поборет бактерии. Стоит отметить, что при запущенности недугов носоглотки у детей могут появиться серьезные осложнения в виде менингита и пневмонии. А это уже заболевания опасные для жизни.

Существуют разнообразные подходы к устранению стафилококков из организма ребенка. Обычно решение о конкретных препаратах и связках методов принимает специалист. Все зависит от тяжести протекания заболевания, на которое указывают конкретные симптомы. Рассмотрим основные способы лечения и их особенности.
- Применение антибиотиков. На начальных этапах специалисты советуют принимать цетриаксон, азитромицин, амоксиклам, ванкомицин и т. п. Не следует забывать, что такие препараты обладают рядом побочных эффектов, и малышам должны назначаться с особой осторожностью. Необходимо дополнительно использовать биопрепараты, чтобы поддержать микрофлору пищеварительной системы.
- Использование стафилококкового бактериофага. Применяется, если стафилококк обнаружили, но осложнения отсутствуют. Курс лечения длится 3 недели. По завершении лечения повторно сдаются анализы и при положительном результате назначаются восстанавливающее препараты.
- Применение растворов на основе морской соли. Препараты с ее содержанием есть в каждом аптечном пункте. Особенно хорошо зарекомендовала себя морская соль. Она не только воздействует на бактерии, но и удаляет избыток сопельного секрета.
- Народные средства. Это, как правило, растворы для промывки полости носа и полоскания горла. Смеси делаются на основе воды и поваренной соли, а также йода. Может применяться и пищевая сода.
С отеком слизистых помогают бороться настойки календулы и ромашки. Для горла хорошо помогают мази на основе эвкалипта. При этом не следует применять сразу все рецепты. Лечение должно быть поэтапным.
Для усиления иммунной функции хорошо подходят пчеловодческие продукты. Бактериальные свойства прополиса активно борются с инфекцией. Употребление меда хорошо снимает неприятные признаки воспаления. Кроме этого, улучшается настроение, ведь употребляя сладкий продукт, всегда приятнее лечиться!
Выводы
Золотистый стафилококк может вызвать множество болезней и неприятных последствий. Однако подавить действие бактерий достаточно просто. Основная проблема здесь заключается в длительном диагностировании. Именно поэтому важно своевременно отвести к доктору своего малыша.
Ну а чтобы снизить вероятность инфицирования золотистым стафилококком ребенку следует вести здоровый образ жизни. Необходимо правильно питаться, соблюдать личную гигиену, проветривать помещение. Кроме этого, детишек нужно отучить от вредных привычек (брать грязные предметы в рот, грызть ногти и т. д.). Все эти меры помогут вашим детям оставаться сильными и здоровыми!
Поделитесь в социальных сетях! comments powered by HyperComments Загрузка…
lechenienasmorka.ru
атрофию слизистой оболочки носа;
Иммунал;
Эфирные масла. Хорошо подходят для обработки кожи: можжевеловое, пихтовое, кедровое, эвкалиптовое и масло чайного дерева. Наносить их на открытые ранки категорически нельзя, только рядом с раной или на почти зажившие. Перед активным использованием желательно проверить кожу на чувствительность и отсутствие аллергии. Для этого стоит нанести совсем немного масла и подождать некоторое время. Если нет сильного покраснения, зуда и жжения – эфирное масло можно использовать. Есть и другой способ использования эфирных масел – распыление их в комнате с помощью аромалампы. Это не только поможет дезинфицировать кожу, но и уничтожит бактерии в комнате.


